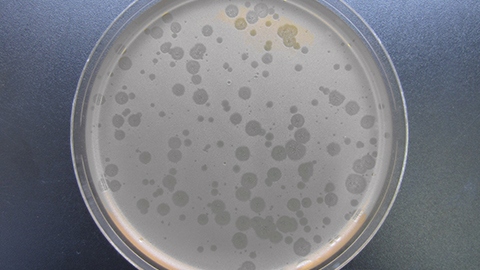

La UAB participa en un projecte per controlar infeccions bacterianes en granges avícoles
Membres del grup de Microbiologia Molecular de la UAB, liderats per la Dra. Montserrat Llagostera, participen en el projecte europeu PhagoVet, dotat amb 3.3 milions d'euros, per desenvolupar tres productes a partir de bacteriòfags per lluitar contra la Salmonella i l'Escherichia coli, que poden afectar aquestes explotacions.
Amb més de 40.000 explotacions avícoles, la Unió Europea és el màxim productor mundial de carn d'aus de corral (unes 13,1 milions de tones cada any) i el segon major productor d'ous (més d'11 milions de tones anuals). A més, la indústria avícola europea genera 302.000 llocs de treball i té una facturació anual de 30 bilions d'euros. La col·libacilosi, provocada per l'E. coli, és una malaltia greu que afecta les aus, les quals també són reservoris naturals de la Salmonella. Aquest bacteri és el responsable de la salmonel·losi humana, amb un impacte econòmic de 3 bilions d'euros a l’any, segons estima l'Autoritat Europea de Seguretat Alimentària (EFSA).
A més, les dades indiquen que diferents pràctiques, com l'ús indiscriminat d'antibiòtics, han provocat un increment de la resistència antibacteriana. S'estima que, a nivell mundial, moren anualment 700.000 persones a causa d'infeccions produïdes per aquests bacteris resistents, i es calcula que aquest nombre arribarà als 10 milions el 2050 si no es prenen mesures correctores.
Un biocida i dos additius alimentaris
En resposta a aquestes greus situacions, el projecte PhagoVet pretén desenvolupar tres tipus de productes, un biocida i dos productes tecnològics additius alimentaris, produïts a partir de bacteriòfags, capaços d'eliminar la Salmonella i l'Escherichia coli de les explotacions aviàries. Serà la primera solució a nivell europeu basada en fags que pot permetre controlar, de forma natural i efectiva, els dos bacteris patògens més comuns de la producció d'aus, evitant els efectes secundaris i els residus associats a l'ús d’antibiòtics. L'ús dels bacteriòfags en producció animal suposa una solució segura per a l’ambient, els animals i els éssers humans.
El projecte s'emmarca dins la iniciativa Fast Track to Innovation del programa Horizon 2020 de la Comissió Europea. Aquesta acció finança propostes innovadores des de la fase de demostració fins a la seva incorporació al mercat. Es preveu, doncs, que el consorci PhagoVet sigui capaç de posicionar en el mercat tres productes de control microbiològic en un període màxim de tres anys. El grup de recerca de la UAB, liderat per la Dra. Montserrat Llagostera, del Departament de Genètica i Microbiologia, ha esdevingut referent en la recerca de bacteriòfags. Ha patentat i llicenciat un producte per a ús alimentari basat també en fags, empresa del qual s'està ultimant l'entrada al mercat.
El projecte PhagoVet està coordinat per Controlvet, grup empresarial portuguès que ofereix serveis de biotecnologia aplicada a la seguretat alimentària. A més de la participació de la UAB, formen part del consorci el Centro de Calidad Avícola de la Comunidad Valenciana (CECAV), la consultora belga VETWORKS BVBA, que dóna suport a projectes de la indústria animal i farmacèutica veterinària, i l'empresa polonesa Phage Consultants, especialitzada en la producció de bacteriòfags a escala industrial.